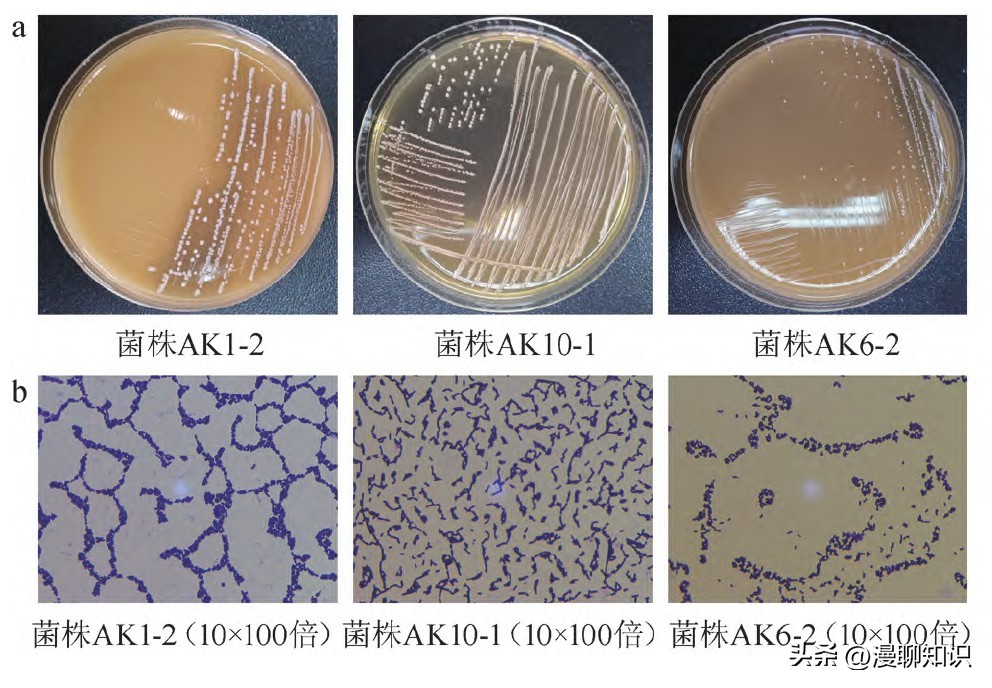
安康鲊广椒细菌是什么？关于它菌群多样性、功能及相关性分析

在阅读此文前,诚邀您请点点右上方的“关注”,既方便您进行讨论与分享,还能及时阅读最新内容,感谢您的支持。
作为粮食作物和人类能量的重要来源,谷物大多富含碳水化合物、蛋白质、维生素、膳食纤维及矿物质等元素,其分布及用量排全球第一。
此外,谷物亦是常用的发酵基质,经微生物、酶和酸等作用,可改善谷物中单宁、植酸等抗营养素的影响,提升谷物风味及在人体内的消化率。
目前,谷物发酵相关产品除常见的酒、醋、酱、酸面团、面包、豆豉和腐乳外,也包括酸粥、红糟、醪糟和鲊广椒等地域特色鲜明的传统食品。

其中,鲊广椒为谷物与鲜辣椒碎辅以食盐混合固态发酵而成的一类产品,既可作为主食也可作为调味品或单独成菜,在湖南、湖北、重庆和贵州大部分地区以及四川、云南和陕西等部分地区较为常见。
近年来,研究人员采用多种技术手段对多地自然发酵鲊广椒类产品微生物、风味及品质开展了较为深入的调研,结果均表明该类产品风味独特、微生物丰富且均以细菌为主,但不同地区鲊广椒中微生物组成及含量存在明显差异,生境亦对其菌群组成存在一定影响。
此外,基于纯培养与分子生物学方法,ZHANG Z等亦从传统自然发酵鲊广椒中分离出多个新物种,说明鲊广椒类样品中有大量的菌株有待发掘。

安康市位于陕西省东南部,地处秦巴山区腹地,境内森林覆盖率较高,汉水穿城而过,素有“八山一水一分田”之称。
安康地区土地虽然较为贫瘠,但有关数据显示其历年玉米产量均占当地主要粮食作物产量首位,且当地鲊广椒亦主要以玉米为原料,不仅丰富了玉米的储存方式,而且增加了居民饮食品类,然而目前尚缺乏针对安康鲊广椒开展的研究。
本研究以安康地区家庭自制鲊广椒为研究对象,通过高通量测序技术解析其细菌群落结构组成,采用纯培养方法结合分子生物学技术对其中乳酸菌进行分离鉴定,并对其细菌序列潜在功能及细菌属间的相关性进行分析。
旨在全面解析安康鲊广椒菌群组成并发掘菌种资源,为后续深入研究提供理论依据与菌株支持。

材料与方法
材料与试剂 原料
鲊广椒:市售。
化学试剂
溶菌酶(2×104 U/mg)、蛋白酶K(≥30 U/mg)、十六烷基三甲基溴化铵、乙二胺四乙酸二钠(ethylene diamine tetraacetic acid-2Na,EDTA-2Na)、Tris碱、异戊醇、氯仿、苯酚:西陇科学股份有限公司;脱氧核糖核苷三磷酸(deoxyribonucleoside triphosphate,d NTP)、浓缩10倍的聚合酶链式反应(polymerase chain reaction,PCR)缓冲液(10×PCR buffer)、重组热稳定脱氧核糖核酸(deoxyribonucleic acid,DNA)聚合酶和p MD18-T载体:宝生物工程(大连)有限公司;111860琼脂糖:香港基因有限公司;6×Loading buffer、2×PCR mix和DL2000 DNA Marker:宝日医生物技术(北京)有限公司;DNeasy mericon Food Kit提取试剂盒:德国QIAGEN公司。
实验所用化学试剂均为分析纯或生化试剂。

培养基
MRS培养基:北京奥博星生物技术有限责任公司;LB(Luria-Bertani)营养肉汤培养基:美国Hyclone公司。
仪器与设备
5810R台式高速冷冻离心机:德国Eppendorf公司;SW-CJ-2D双人单面超净工作台:苏州净化设备有限公司;DG250厌氧培养箱:英国DWS公司;ECLIPSE Ci生物显微镜:日本Nikon公司;LRH-70生化培养箱:上海一恒科技有限公司;ZD-85气浴恒温振荡器:常州金坛宏华仪器厂;Veriti96孔梯度PCR仪:美国Applied Biosystems公司;DYY-12电泳仪:北京六一仪器厂;UVP CDS-8000凝胶成像分析系统:美国Bio-Rad公司;YXQ-sⅡ立式压力蒸汽灭菌锅:上海博迅实业有限公司医疗设备厂。

方法
样本采集与前处理
从陕西省安康市不同菜市场采集鲊广椒样本10份(编号为AK1~AK10),样本均为农户以玉米粉和辣椒碎为原料添加适量食盐采用自然发酵制作而成。
每份样本采集500 g,分装于无菌离心管中,用于高通量测序的样本置于-20℃,用于分菌的样本暂存于4℃,尽快完成后续操作。
宏基因组DNA提取与PCR扩增
使用商业试剂盒进行样本基因组DNA提取,扩增产物使用微量紫外分光光度计测定浓度。
提取的目标序列可参照GUO H等的方法利用338F(5'-ACTCCTACGGGAGG-CAGCAGC-3')/806R(5'-GGACTACHVGGGTWTCTAAT-3')引物对进行扩增。

高通量测序与生物信息学分析
DNA扩增产物低温寄至测序公司进行序列鉴定。
公司返回的序列使用QIIME(v1.7)分析平台进行序列拼接、去除嵌合体、去除引物等质量控制操作。
根据高质量序列间的相似性划分分类操作单元(operational taxonomic unit,OTU),同时对序列进行α多样性和β多样性分析,然后利用数据库判定各序列的微生物分类地位。
将序列上传至服务器并利用PICRUSt1分析其潜在功能特性。
乳酸菌分离纯化
参照GB 4789.35—2016《食品微生物学检验乳酸菌检验》中的方法对样本进行逐级稀释,然后取0.1 m L涂布于无菌MRS琼脂平板中,37℃厌氧培养48 h。
依据菌落形态及颜色挑选单克隆进行纯化、镜检和保藏。

菌株DNA提取与鉴定
参照夏海燕所述十六烷基三甲基溴化铵(cetyl trimethyl ammonium bromide,CTAB)-十二烷基硫酸钠(sodium dodecyl sulfate,SDS)-溶菌酶法(CTAB-SDS-溶菌酶法)提取各分离株DNA序列,以其为模板,利用细菌通用引物27F(5'-AGAGTTTGATCCTGGCTCAG-3')/1495R(5'-CTACGGCTACCTTGTTACGA-3')扩增菌株16S r DNA序列,继而应用琼脂糖凝胶电泳检测扩增产物是否合格。
使用清洁试剂盒去除扩增产物中的杂质后,采用热激法将DNA序列导入到感受态大肠杆菌细胞中,利用引物对M13F(5'-CGCCAGGGTTTTCCCAGTCACGAC-3')/M13R(5'-GA-GCGGATAACAATTTCACACAGG-3')扩增及鉴定阳性克隆,将合格阳性克隆寄出测序。

数据分析及可视化
高通量测序数据分析采用Origin 2022、R(v4.0.0)和Gephi(v0.9.2)进行可视化,其中堆积柱状图用于展示各样本中细菌菌属构成,应用相关性网络分析图对细菌属间相关性进行分析。
应用美国国立生物技术信息中心(national center for biotechnology information,NCBI)(https://www-ncbi-nlm-nih-gov.webvpn.bjmu.doc110.com/)的Gen Bank数据库在线分析分离菌株所属类别,各分离株间的进化关系树利用MEGA7、DNAMAN和Bio Edit实现。

结果与分析
安康鲊广椒细菌菌群多样性分析
从安康10份自然发酵鲊广椒*共中**计检测出204 315序列,对各样本Alpha多样性指数进行解析,结果见表1。

表1 Alpha多样性分析结果
注:肩标为*的指数均为测序深度为8 010条序列时计算所得。
由表1可知,鲊广椒样本中细菌序列数范围为8 942~36 231条,发现的物种数由85~258个不等。
对比超1指数,样品AK2的超1指数值较其他样品高,而样品AK7的超1指数值最小,表明样品AK2细菌总数最多。
此外,样品AK7的香农指数和辛普森指数值均为最小,表明其细菌多样性较低。
α多样性指数分析结果显示,安康鲊广椒中细菌丰富度和均匀度不同。
为探究各样本细菌群落结构组成,本研究进一步对序列分类进行分析。
按照97%的相似度可将合格序列划分至1 238个OTU中,从各OTU中提取代表性序列进行比对,得到各微生物学分类地位数量分别为门9个,纲21个,目37个,科68个,属106个,各样本中细菌门及优势细菌属(平均相对含量>0.1%)分布情况见图1。

由图1a可知,安康鲊广椒中细菌主要隶属于厚壁菌门(Firmicutes)、变形菌门(Proteobacteria)、放线菌门(Actinobacteria)、拟杆菌门(Bacteroidetes)、糖细菌门(TM7)、蓝菌门(Cyanobacteria)、梭杆菌门(Fusobacteria)、螺旋体门(Spirochaetes)、异常球菌-栖热菌门(Deinococcus-Thermus),其中Firmicutes平均相对含量高达97.04%,为安康鲊广椒中的绝对优势细菌,其次为Proteobacteria(2.53%)。
由图1b可知,属水平上,各样本中细菌组成及丰度不同,总体上乳酸杆菌属(Lactobacillus)、魏斯氏菌属(Weissella)、克雷伯氏菌属(Klebsiella)、片球菌属(Pediococcus)、海洋芽胞杆菌属(Oceanobacillus)、泛菌属(Pantoea)、假黄色单胞菌属(Pseudoxanthomonas)和伯克霍尔德菌(Burkholderia)为其优势菌属,且Lactobacillus含量远高于其他菌属,在各样本中的相对含量均在88%以上。
采用高通量测序技术,研究人员发现湖北天门、洪湖和秭归等地鲊广椒中绝对优势细菌属亦为Lactobacillus,表明该属菌株在鲊广椒发酵过程中发挥重要作用。
此外,本研究所有样本中均检测出了Lactobacillus、Weissella、Klebsiella,表明这些细菌属为安康鲊广椒中的核心菌属。

图1 基于门(a)和属(b)水平鲊广椒样品细菌菌群结构
安康鲊广椒细菌菌群功能分析
微生物生长代谢对于发酵食品品质有着重要的影响,为探究细菌在安康鲊广椒中的功能,进一步利用直系同源蛋白数据库对其细菌序列潜在功能进行分析,结果见图2。
由图2可知,安康鲊广椒细菌序列潜在功能可分为23个大类,不同样本中具有同一功能大类的序列数占总序列数的比例有所差别,但总体上在一般功能(R)和未知功能(S)方面占比最高,其次为氨基酸转运与代谢(E)、碳水化合物运输和代谢(G)及翻译、核糖体结构与生物发生(J),三者序列占比均在8.0%以上。
安康鲊广椒多以玉米粉为主要原料进行发酵,含有丰富的蛋白质、碳水化合物及脂肪等营养成分,发酵过程中具有氨基酸转运与代谢及碳水化合物运输和代谢等潜在功能的细菌占比高,一方面有利于微生物利用底物生长,另一方面可促使原料中的大分子营养成分分解。

图2 鲊广椒细菌序列基因功能预测
相关性分析
目前各地制作鲊广椒均采用自然发酵,多种微生物参与其*共中**同形成成品独特的风味与口感。
为探究安康鲊广椒发酵过程中各类微生物间的相互作用,对安康鲊广椒中平均相对含量>0.1%的细菌属间的相关性进行了分析,结果见图3。

图3 平均相对含量>0.1%细菌属间的相关性
由图3可知,样本中平均相对含量>0.1%的27个细菌属间存在复杂的相关关系,共同构成了安康鲊广椒稳定的微生物群落结构,其中Klebsiella与17个细菌属间存在明显相关性,Pantoea与12个细菌属相关,其次为Microbacterium和Pseudomonas,与二者分别呈现显著相关性的细菌属各有10个,表明这些菌属在维持安康自然发酵鲊广椒细菌群落结构稳定方面有着重要作用。
总体上,各细菌属多为正相关关系,而Lactobacillus和Pediococcus与多个细菌属间均呈现显著负相关(P<0.05)。
有研究表明,Lactobacillus代谢碳水化合物能力较强,产生的大量乳酸会造成生境酸度增加,从而影响其他微生物的生长,此外乳酸杆菌属和片球菌属部分菌株的代谢物特别是细菌素等具有抑菌作用,这可能是导致这两类细菌属与其他菌属呈现明显负相关性的重要原因。

安康鲊广椒乳酸菌资源挖掘与鉴定
前期基于高通量测序技术发现安康鲊广椒中含有大量的乳酸菌,为样本中的绝对优势细菌。
采用纯培养技术本研究从10份安康自然发酵鲊广椒样本*共中**分离保藏25株纯种菌株,部分菌株群落及细胞形态见图4。
图4 部分分离菌株的菌落形态(a)与细胞形态(b)
由图4a可知,从安康鲊广椒中分离的菌株在MRS平板上厌氧培养后菌落周缘整齐呈圆形、表面光滑湿润,不同菌株菌落大小不一,但多呈白色或乳白色,少部分菌落偏透明。
纯化保藏过程中发现,部分菌株菌落或菌泥较黏,接种环挑起拉丝明显,表明可能产生了胞外多糖,乳酸菌胞外多糖性能独特,黏性及持水性良好,同时具有抑菌、抗氧化、吸附重金属等特性,在食品、医药及农业领域应用广泛。
由图4b可知,分离菌株均为革兰氏阳性无芽孢细菌,细胞无鞭毛、不运动,呈杆状、短杆状、成对、短链或单个存在,符合乳酸菌基本形态特征。
为确定各分离株的微生物分类地位,采用NCBI数据库,并基于16S r DNA基因序列构建系统发育树,结果见图5。

由图5可知,经比对,保藏的25株菌株可划分为10个种,其中菌株AK2-5、AK6-3、AK5-1和AK7-4与弯曲广泛乳杆菌(Latilactobacillus curvatus)DSM 20019及弯曲广泛乳杆菌(Latilactobacillus curvatus)NBRC 15884聚在同一分枝,菌株AK1-2、AK5-2和AK8-3与清酒广泛乳杆菌(Latilactobacillus sakei)NBRC 15893、清酒广泛乳杆菌清酒亚种(Latilactobacillus sakei subsp.sakei)DSM 20017的相似度均在99.90%以上,菌株AK4-2与酸鱼联合乳杆菌(Ligilacto bacillus acidipiscis)NBRC 102163、菌株AK9-2与布氏迟缓乳杆菌(Lentilactobacillus buchneri)JCM 1115、菌株AK9-5与斯比氏促生乳杆菌(Levilactobacillus spicheri)LTH 5753亲缘关系较近,菌株AK1-1、AK1-4和AK6-2与短促生乳杆菌(Levilactobacillus brevis)ATCC 14869=DSM 20054的相似度均高于99.70%,AK10-1和AK7-1与消化伴生乳杆菌(Companilactobacillus alimentarius)DSM 20249较相似,菌株AK3-3、AK7-2、AK2-4、AK2-2、AK9-4、AK3-1、AK5-3和AK7-3与植物乳植物杆菌(Lactiplantibacillus plantarum)NBRC 15891及植物乳植物杆菌(Lactiplantibacillus plantarum)JCM 1149聚在一个分枝且分枝置信度为98.00%,AK6-1和AK8-4分别与类肠膜魏斯氏菌(Weissella paramesenteroides)NRIC 1542和肠膜明串珠菌(Leuconostoc mesenteroides)NBRC 100496的亲缘关系较近。
鉴定到的Latilactobacillus、Ligilactobacillus、Lentilactobacillus、Levilactobacillus、Com panilactobacillus和Lactiplantibacillus均由原Lactobacillus重新划分而来,表明分离菌株亦以乳酸杆菌属为主,这与高通量测序结果一致。

图5 基于16S r DNA基因序列分离菌株的系统发育树
本研究对安康鲊广椒的微生物多样性、功能及相关性进行研究,结果表明,安康鲊广椒微生物丰富多样,细菌隶属于9个门的106个属,其中乳酸杆菌属占绝对优势。
分离的25株乳酸菌,包括植物乳杆菌(Lactiplantibacillus plantarum)8株,弯曲广泛乳杆菌(Latilactobacillus curvatus)4株,短促生乳杆菌(Levilactobacillus brevis)和清酒广泛乳杆菌(Latilactobacillus sakei)各3株,消化伴生乳杆菌(Companilacto bacillus alimentarius)2株及酸鱼联合乳杆菌(Ligilactobacillus acidipiscis)、布氏迟缓乳杆菌(Lentilactobacillus buchneri)、斯比氏促生乳杆菌(Levilactobacillus spicheri)、类肠膜魏斯氏菌(Weissella paramesenteroides)和肠膜明串珠菌(Leuconostoc mesenteroides)各1株。
功能分析结果显示,具有氨基酸转运与代谢、碳水化合物运输、代谢及翻译、核糖体结构与生物发生功能的序列均占总序列数的8.0%以上。
Klebsiella与17个细菌属间存在明显相关性,Pantoea与12个细菌属相关,其次为Microbacterium和Pseudomonas,与二者分别呈现显著相关性的细菌属各有10个,表明这些菌属在维持安康自然发酵鲊广椒细菌群落结构稳定方面有着重要作用。
总体上,各细菌属多为正相关关系,而Lactobacillus和Pediococcus与多个细菌属间均呈现显著负相关(P<0.05)。
《谷物发酵产品的营养功能提升与益生功能研究进展》
《扩增区域对鲊广椒细菌Mi Seq测序的影响》
《遵义地区莽椒细菌多样性及PICRUSt基因功能预测分析》